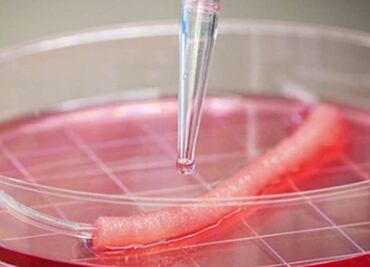
Universidad sueca despide a científico por violar ética médica

Jonathan Sánchez ganó el segundo lugar en un concurso en la NASA, donde compitió contra jóvenes de 45 países con un proyecto para investigar si puede haber vida en Júpiter

Jonathan Sánchez ganó el segundo lugar en un concurso en la NASA, donde compitió contra jóvenes de 45 países con un proyecto para investigar si puede haber vida en Júpiter

El futuro me pertenece: Nikola Tesla” se convirtió en una de las exposiciones más visitadas en la historia del Centro Nacional de las Artes (Cenart), donde del 9 de marzo al 12 de junio reunió a más de 120 mil personas.

El también físico nuclear murió este martes. Aún se desconoce la causa
Paolo Macchiarini fue integrante del equipo que realizó el primer trasplante de tráquea fabricada con células madre del paciente

Desde la casa del "Gran hermano", Enrique Vera pretende dar a conocer proyectos en beneficio de la sociedad



